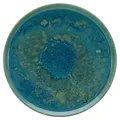
Produktbild: CreaTable Speiseteller YUKI, Speiseteller, Hellblau, Weiß, Ø 28 cm
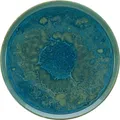
Produktbild: Speiseteller - Hellblau - Weiß seidenmatt - Ø 28 cm - Steinzeug - mit Reaktivglasur
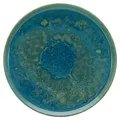
Produktbild: Creatable Yuki Speiseteller Teller Steinzeug hellblau Ø 28 cm

CreaTable Speiseteller YUKI, Hellblau, Ø 28 cm Einzigartiger Speiseteller mit Effektglasuren, die jedes Stück zum Unikat machen - ideal für stilvolle Tischdekoration.
- Hersteller: CreaTable
- Farbe: blau
Preisvergleich ab 22,89 € bis 22,89 €
-
Bestes Angebot
CreaTable Speiseteller YUKI, Speiseteller, Hellblau, Weiß, Ø 28 cm
Durch Effektglasuren entstehen bei diesem Geschirr einzigartige Dekore, die jedes Teil zu einem Unikat machen. Diese gewollten Unregelmäßigkeiten und Unebenheiten, die während des Herstellungsprozesses entstehen, machen den besonderen Charme dieses Geschirrs aus. So gleicht kein Teil dem anderen.

22,89 €
zzgl. 0,00 € VersandCreaTable Speiseteller YUKI, Speiseteller, Hellblau, Weiß, Ø 28 cm
Durch Effektglasuren entstehen bei diesem Geschirr einzigartige Dekore, die jedes Teil zu einem Unikat machen. Diese gewollten Unregelmäßigkeiten und Unebenheiten, die während des Herstellungsprozesses entstehen, machen den besonderen Charme dieses Geschirrs aus. So gleicht kein Teil dem anderen.
-
Speiseteller - Hellblau - Weiß seidenmatt - Ø 28 cm - Steinzeug - mit Reaktivglasur
Speiseteller in hellblaumit einem Durchmesser von 28 cmaus Steinzeug mit Reaktivglasuraußen in seidenmattem weißspülmaschinenfest und mikrowellengeeignet Durch Effektglasuren entstehen bei diesem Geschirr einzigartige Dekore, die jedes Teil zu einem Unikat machen. Diese gewollten Unregelmäßigkeiten und Unebenheiten, die während des Herstellungsprozesses entstehen, machen den besonderen Charme dieses Geschirrs aus. So gleicht kein Teil dem anderen. Marke: Creatable Material: Steinzeug Paket Standard Farbe: Hellblau Farbe: Weiß Eigenschaften: Mikrowellengeeignet Eigenschaften: Spülmaschinengeeignet Durchmesser: 28 cm Lieferumfang: 1 Speiseteller Höhe: 3 cm Artikel-Nummer 002230009702000

22,89 €
zzgl. 0,00 € VersandSpeiseteller - Hellblau - Weiß seidenmatt - Ø 28 cm - Steinzeug - mit Reaktivglasur
Speiseteller in hellblaumit einem Durchmesser von 28 cmaus Steinzeug mit Reaktivglasuraußen in seidenmattem weißspülmaschinenfest und mikrowellengeeignet Durch Effektglasuren entstehen bei diesem Geschirr einzigartige Dekore, die jedes Teil zu einem Unikat machen. Diese gewollten Unregelmäßigkeiten und Unebenheiten, die während des Herstellungsprozesses entstehen, machen den besonderen Charme dieses Geschirrs aus. So gleicht kein Teil dem anderen. Marke: Creatable Material: Steinzeug Paket Standard Farbe: Hellblau Farbe: Weiß Eigenschaften: Mikrowellengeeignet Eigenschaften: Spülmaschinengeeignet Durchmesser: 28 cm Lieferumfang: 1 Speiseteller Höhe: 3 cm Artikel-Nummer 002230009702000
-
Creatable Yuki Speiseteller Teller Steinzeug hellblau Ø 28 cm
Produktart: Speiseteller, Material: Steinzeug, Farbe: Blau, Höhe: 3 cm

22,89 €
zzgl. 0,00 € VersandCreatable Yuki Speiseteller Teller Steinzeug hellblau Ø 28 cm
Produktart: Speiseteller, Material: Steinzeug, Farbe: Blau, Höhe: 3 cm
Gut zu wissen
Ähnliche Produkte

Greengate Speiseteller Dinner Teller Alice Dark Blue (26,5cm)
23,20 €
Amazon.de

Rosenthal Speiseteller Junto Aquamarine 27cm - Eleganter Speiseteller aus hochwertigem Porzellan, ideal für stilvolle Tischkultur und besondere Anlässe.
26,92 €
Amazon.de

Greengate Speiseteller Alice - Farbenfroher Steingut Speiseteller aus der Serie Alice, perfekt kombinierbar für einen individuellen Tischlook und bringt frischen Schwung in deinen Alltag.
24,09 €
Amazon.de

like. by Villeroy & Boch Organic Turquoise Speiseteller 30 cm - Eleganter Porzellan Speiseteller, spülmaschinenfest und mikrowellensicher - ideal für stilvolle Tischdekoration.
21,63 €
Amazon.de

Thomas Trend Colour Night Blue Speiseteller 26 cm Trend Colour Night Blue 11400-401920-10226
17,35 €
Amazon.de

Greengate Teller ALICE Blau 23 cm Kuchenteller Everyday Geschirr PALE BLUE
15,04 €
Amazon.de

Greengate Plätzchenteller ALICE PALE BLUE Blau Everyday Geschirr Kuchenteller
18,44 €
Amazon.de

Thomas Trend Colour Ice Blue Speiseteller 28 cm Trend Colour Ice Blue 11400-401921-10229
16,95 €
Amazon.de

BITZ Teller, Speiseteller, Essteller aus Steinzeug, 27 cm im Durchmesser, schwarz/dunkelblau
16,39 €
Amazon.de

SELTMANN WEIDEN Speiseteller - 27,7 cm rund mit Rillenrelief in Arktisblau, künstlerischer Aquarell-Effekt für einen modernen Tischstil, mikrowellen- und spülmaschinenfest
18,14 €
Amazon.de